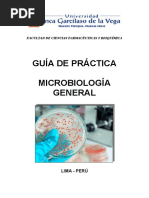

Universidad Central del Ecuador
Facultad de Ciencias Médicas
Carrera de laboratorio clínico
Nombre: Shirley Jacqueline Peralvo Pérez
Fecha: 12-05-2021
Asignatura: Bacteriología Docente: Msc. Claudia Gavilánez
1. TEMA :Laboratorio de microbiología
2. OBJETIVO GENERAL
Conocer lo que se maneja dentro del laboratorio de microbiología, para definir qué
equipos y materiales vamos a manipular en las actividades desarrolladas en el
laboratorio mediante una revisión bibliográfica.
3. MARCO TEORICO
3.1. ¿Qué es la microbiología?
La Microbiología es una rama de la biología que se ocupa del estudio de microorganismos,
como las bacterias, los hongos o los virus. Todos ellos son esenciales en nuestra vida, ya
que están presentes en cualquier hábitat. Los microorganismos son seres vivos de tamaño
de muy pequeño que no se pueden ver a simple vista. Para ello, se requiere de un
microscopio, por lo que para el estudio es necesario obtener miles o millones de individuos.
(1)
3.2. Que es un laboratorio de microbiología?
Un laboratorio de microbiología es un establecimiento que realiza evaluaciones
microscópicas, tanto para prevenir o ejecutar diagnósticos, después de tomar y recibir
muestras biológicas y parasitológicas. En este sentido, se tiene como objetivo principal
identificar los microorganismos que causan las enfermedades, para poder recibir un
tratamiento adecuado. Como puedes comprobar, el papel que se realiza en este tipo de
laboratorios es esencial para nuestra sociedad y, sobre todo, para nuestra salud y bienestar.
(1)
Por otro lado, al ser un centro para la salud, debe ser un sitio seguro, cómodo y eficiente.
Por ello, se deben tomar medidas de higiene y seguridad, tanto para el personal que allí
labora, como para las personas que acudan a él. Además debe poseer un lugar de
almacenamiento para la respectiva toma de las muestras. Muchos cultivos y
comprobaciones no pueden llevarse a cabo si no se dan una serie de condiciones muy
concretas de temperatura, humedad, etc. Por ello, es esencial que el estado de un laboratorio
de microbiología esté siempre donde debe estar. (1)
Pá gina 1
�Para deshacerse del material contaminado se deben utilizar recipientes adecuados que
deben ser esterilizados posteriormente.
Nunca se puede tirar nada contaminado por el fregadero o al cubo de la basura común sin
haber sido esterilizado previamente.
El laboratorio deben existir unas recomendaciones generales de limpieza y en caso de
vertidos:
- Procedimientos de limpieza de superficies externas mediante papel humedecido con
solución desinfectante (alcohol 70%, desinfectante fenólico diluido, etc.). Aclarar
con agua los restos de desinfectante.
- En caso de usar soluciones de hipoclorito en zonas metálicas, limpiar
posteriormente para evitar el efecto corrosivo.
- En caso de derramamientos de material peligroso o formación de aerosoles: evitar
inspiraciones de esos aerosoles, esperar 30 minutos hasta que las partículas se hayan
depositado y limpiar con mascarilla, guantes y otros útiles protectores.
- En caso de vertido de materiales, cubrir la superficie con desinfectante y
posteriormente cubrir con papel humedecido con desinfectante. Dejar durante 15
minutos y limpiar. En caso necesario aclarar con agua.
- En caso de derramamientos menores limpiar el material vertido mediante papel
humedecido y posteriormente aclarar, cuando sea necesario. (2)
3.3. Estructura de un laboratorio de Microbiología Clínica
Área administrativa
Área de recepción de muestras
Área de extracción que deberá:
o Disponer de material de un solo uso para contacto con muestras biológicas
o Disponer de un área de extracciones y toma de muestra, una sala de espera para los
pacientes y los servicios de higiene correspondientes.
o Disponer de personal legalmente autorizado para la toma de muestras
o Disponer de un manual de extracción, toma y transporte de muestras.
El manual antedicho deberá ser elaborado por el responsable
Área de trabajo: análisis y procesado de muestras
- El puesto de trabajo debe debe de estar limpio y ordenado. El material necesario
debe prepararse antes de empezar a trabajar y colocarse de forma adecuada para que
se facilite su utilización así se evitarán accidentes y se minimizará el riesgo de
contaminación
Pá gina 2
� - Nunca se debe pipetear con la boca. Utilizar siempre elementos manuales o
automáticos.
- Todo el material utilizado debe estar estéril. (2)
Elementos y materiales más frecuentes de un laboratorio de Microbiología Clínica
Mesas de laboratorio y fregadero
Mechero Bunsen
Estufa de incubación
Es una cámara de temperatura controlada para cultivo de
microorganismos.
Se utiliza para facilitar el desarrollo de los microorganismos a su
temperatura óptima de crecimiento (generalmente 35-37º).
Frigorífico o cámaras refrigeradas
Se utilizan para conservar tanto materiales (medios de cultivo, reactivos)
como microorganismos.
Generalmente están a una temperatura fija de 4ºC.
Congeladores
Se utilizan para la conservación de reactivos y microorganismos a
temperaturas inferiores a 0ºC, llegando a -80ºC (los más frecuentes son -
20º, -40º y -80º).
Microscopio óptico
Pá gina 3
� Centrífuga
Aparato que aplica sobre los tubos una fuerza centrífuga lo que
permite la separación de los distintos componentes de la muestra
mediante la precipitación en el fondo del tubo de las partículas en
suspensión.
Cámaras de seguridad biológica
Contador de colonias: Es un aparato que mediante la
iluminación de la placa y una lupa, nos permite observar con
mayor nitidez las colonias y por tanto facilita su recuento.
Balanzas
Agitador/ mezclador
Vor tex
Asas de siembra:
Se utilizan para sembrar. Pueden ser metálicas o de
plástico, curvas o rectas (para la siembra por picadura).
Ph-metros:
Pá gina 4
�
Material fungible
Placas de Petri: recipientes para la preparación de medios de
cultivo sólidos
Placas de Petri con medio sólido
Tubos con medio líquido
Tubos con medio sólido
Pipetas de vidrio, de plástico y
pipeteadores.
Pi peta manual
Pipetas automáticas (micropipetas) y puntas de pipeta:
Se utilizan para pipetear pequeñas cantidades de líquidos.
Se utilizan con puntas desechables de distinto tamaño y color
según la micropipeta. Existen cuatro tamaños: de 0,5-2µm; de
2-20 µm; de 20-200 µm y de 200-1000 µm.
Asas acodadas o Asas de Digralsky:
Se utilizan para la extensión de microorganismos sobre la
superficie de un medio de cultivo en placa Petri.
Pá gina 5
�
Portas y cubres
Para realizar las observaciones al microscopio.
Vasos de precipitados y matraces
Cucharas y espátulas:
Se utilizan para pesar muestras o medios de cultivo.
Área de limpieza de material y eliminación de residuos
Zona donde se procede a la esterilización mediante autoclave del material utilizado. El
material desechable se elimina y con el material reciclable se procede a la eliminación de
residuos y lavado. De esta manera el material queda dispuesto para ser utilizado.
Área de esterilización
Procedimiento por el que se consigue la muerte de todos los organismos vivos y formas de
resistencia en un objeto o producto tratado.
Autoclave
Es el equipo más utilizado.
Es un procedimiento de esterilización mediante calor húmedo. Se
realiza en al autoclave durante 15 ó 20 min, según el volumen, a
115°C ó 121°C, según la naturaleza del material que se desee
esterilizar.
Horno de Pasteur: emplea altas temperaturas (160-180º C)
durante un tiempo prolongado (1.5 a 3 horas). Debido a su poca
capacidad de penetración se usa para esterilizar vidrio y metales.
Pá gina 6
� Actúa principalmente desnaturalizando las proteínas y secundariamente oxidando
los compuestos celulares
Área de preparación de medios
Almacén de reactivos
Área de seguridad microbiológica
Debe ser una zona diferenciada y aislada para la manipulación de microorganismos
susceptibles de formar aerosoles potencialmente infecciosos. (2)
3.4. Nivel de bioseguridad en el laboratorio de microbiología
Nivel de Bioseguridad 2. Las prácticas, los equipos, el diseño y la construcción de
instalaciones del Nivel de Bioseguridad 2 son aplicables a laboratorios educativos,
de diagnóstico, clínicos u otros laboratorios donde se trabaja con un amplio espectro
de agentes de riesgo moderado que se encuentran presentes en la comunidad y que
están asociados con enfermedad humana de variada gravedad. (2)
Barreras secundarias en laboratorios de bioseguridad 2
Las puertas deben cerrarse automáticamente y han de tener cerraduras de acuerdo
con las directrices de la institución. Además, deben llevar las necesarias señales de
riesgo biológico.
Deben existir piletas para el lavado de manos; se recomiendan las controladas con
los pies, las rodillas o las que operan automáticamente. Deben localizarse cerca de
las puertas de salida.
El diseño ha de facilitar la limpieza y descontaminación.
El mobiliario debe ser capaz de soportar cargas y usos anticipados. Su superficie
debe ser impermeable y resistente al calor, solventes orgánicos, ácidos, álcalis y
otros productos químicos.
No se recomiendan ventanas que puedan abrirse al exterior. No existen requisitos de
ventilación específicos. Sin embargo, cuando se planifique una nueva instalación
habrá que prever un sistema mecánico de ventilación que introduzca aire del
exterior sin recirculación a espacios fuera del laboratorio. Cuando no se disponga de
ventilación mecánica, las ventanas deberán poder abrirse, y deberán estar provistas
de mosquiteras.
Deben disponer de cabinas de seguridad biológica (CSB), situadas lejos de posibles
alteraciones del flujo aéreo, como puertas, ventanas, áreas de gran flujo de trabajo.
Las CSB deben tener un sistema de filtrado y recirculación de aire verificado.
Se debe disponer de una estación para el lavado de ojos, así como de duchas para
casos de urgencia.
Se debe disponer de un sistema de descontaminación de desechos (por ejemplo:
autoclave, desinfección química, incineración, u otro método validado). (4)
Pá gina 7
�4. CONCLUSIONES
Es importante tomar en cuenta que en el laboratorio de microbiología únicamente
pueden tener acceso es el personal autorizado es decir los profesionales de
laboratorio o en otros casos los bioquímicos, lo importante es que posea la
capacitación necesaria.
Un punto clave que se debe tomar muy en cuenta es que las puertas se deben
encontrar siempre cerradas, debido a una posible contaminación que se puede dar
tanto desde el interior del laboratorio hacia el exterior como viceversa.
Un laboratorio de microbiología en su infraestructura mínimo debe cumplir los
requisitos del nivel 2 sin embargo, lo más preferible es que consten de un tercer
nivel de bioseguridad lo cual un punto muy importante para basarse en el nivel de
bioseguridad que se requiera en el laboratorio va a depender del grupo de riesgo
que se maneje.
5. BIBLIOGRAFÍA
1. Euroinnova Business School. ¿Qué es y qué se hace en un laboratorio de
microbiología? [Internet]. Euroinnova Business School. 2021 [citado el 11 de
mayo de 2023]. Disponible en: https://www.euroinnova.ec/que-es-y-que-se-
hace-en-un-laboratorio-de-microbiologia
2. RC. Laboratorio Microbiologia [Internet]. Usal.es. [citado el 11 de mayo de
2023]. Disponible en:
https://campus.usal.es/~micromed/Practicas_odontologia/unidades/labv/
LabMicro/practica1.html
3. Manual de Bioseguridad para Establecimientos de Salud – Capítulo 18
Bioseguridad En Laboratorios De Microbiología [Internet]. Gov.ar. [citado el 12
de mayo de 2023]. Disponible en:
https://www.mendoza.gov.ar/salud/biblioteca/manuales/manual-de-
bioseguridad-para-establecimientos-de-salud-capitulo-18-bioseguridad-en-
laboratorios-de-microbiologia/
4. Alados JC, Alcaraz MJ, Aller AI, Miranda C, Pérez JL, Romero PA. Diseño de
un laboratorio de microbiología clínica. Enferm Infecc Microbiol Clin [Internet].
2010 [citado el 12 de mayo de 2023];28(7):453–60. Disponible en:
https://www.elsevier.es/es-revista-enfermedades-infecciosas-microbiologia-
clinica-28-articulo-diseno-un-laboratorio-microbiologia-clinica-
S0213005X0900408X
Pá gina 8